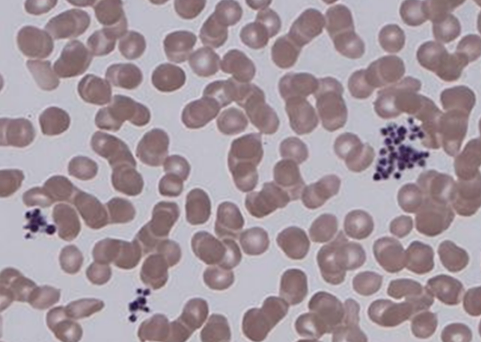

[RES22]
0
여기에 표시한 문제들은 마이노트에서 모아볼 수 있어요!
29세 여성이 정기 건강 검진에서 혈소판 수치가 비정상적으로 낮게 나왔다며 병원을 방문했다. 그녀는 출혈이나 멍이 드는 증상을 경험하지 않았다고 말했다. 혈액검사 결과와 말초혈액도말 사진이다. 필요한 처치는?
WBC 5,200/mm3, Hb 12.9 g/dL, platelet 28,000/mm3
정답률 96%
누적 풀이 횟수 1,900+
평균 풀이 시간12초
/
나의 풀이 시간0초
Imp: 거짓혈소판감소증(pseudothrombocytopenia)
해설
특이 증상 없이 검진 CBC상 thrombocytopenia로 내원한 환자이며, PB smear상 platelet agglutination이 확인되므로 pseudothrombocytopenia가 의심된다. 이런 경우 heparin tube 또는 sodium citrate tube를 이용한 재검을 먼저 실시한다.
오답 선지
• 혈소판 수혈, 혈장교환술, 스테로이드: 진성 혈소판감소증이 확인된 경우 고려할 수 있다. 혈소판 수혈은 수혈 적응증에 따라 시행하며, 혈장교환술은 주로 TTP의 치료로, 스테로이드는 ITP, TTP 등의 치료로 사용된다.
• 골수검사: Hb, WBC count 이상소견이 동반되어 hematologic malignancy가 의심될 경우 고려할 수 있다.
관련 이론
• 혈전성혈소판감소자반증
• 혈소판감소증의 접근
• 혈소판감소증의 분류
Reference
• Harrison 21e, pp.450-457